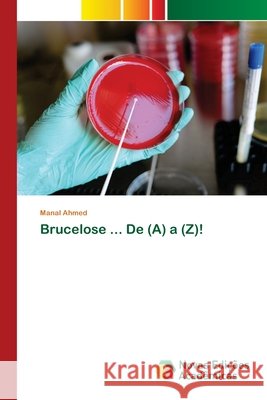
Brucelose ... De (A) a (Z)! Ahmed, Manal 9786200797414

Wyniki wyszukiwania:
wyszukanych pozycji: 365
 |
Mum... I wanna change my world
ISBN: 9781524597429 / Angielski / Miękka / 2017 / 28 str. Termin realizacji zamówienia: ok. 16-18 dni roboczych. |
cena:
120,70 |
 |
L'io, lo spazio e il tempo
ISBN: 9786207577088 / Włoski Termin realizacji zamówienia: ok. 10-14 dni roboczych. |
cena:
273,68 |
 |
Acute Pain Management Using Non Pharmacological Intervention
ISBN: 9783659166143 / Angielski / Miękka / 2012 / 240 str. Termin realizacji zamówienia: ok. 10-14 dni roboczych. |
cena:
355,03 |
 |
Drowning In Darkness
ISBN: 9789697493241 / Angielski / Miękka / 2025 / 108 str. Termin realizacji zamówienia: ok. 16-18 dni roboczych. |
cena:
31,97 |
 |
The Effect Of Using Facebook On Improving English Language Writing Skills And Vocabulary Enrichment
ISBN: 9786139472642 / Angielski Termin realizacji zamówienia: ok. 10-14 dni roboczych. |
cena:
246,72 |
 |
Il calvario delle élite maghrebine europeizzate
ISBN: 9786204500959 / Włoski / Miękka / 92 str. Termin realizacji zamówienia: ok. 10-14 dni roboczych. |
cena:
273,68 |
 |
Staphylococcus Aureus resistente alla meticillina
ISBN: 9786204091815 / Włoski / Miękka / 2021 / 128 str. Termin realizacji zamówienia: ok. 10-14 dni roboczych. |
cena:
278,18 |
 |
From Marketing to Meaning: The Power of Authenticity in the Social Media Age
ISBN: 9781445770802 / Angielski / Miękka / 2024 / 484 str. Termin realizacji zamówienia: ok. 16-18 dni roboczych. |
cena:
125,94 |
|
Brucelose ... De (A) a (Z)!
ISBN: 9786200797414 / Portugalski / Miękka / 2020 / 160 str. Termin realizacji zamówienia: ok. 10-14 dni roboczych. |
cena:
323,12 |
 |
Women Resisting Sexual Violence and the Egyptian Revolution: Arab Feminist Testimonies
ISBN: 9781786996213 / Angielski / Twarda / 2020 / 272 str. Termin realizacji zamówienia: ok. 30 dni roboczych. |
cena:
392,62 |
 |
Non-Newtonian Properties of Fruit Concentrates
ISBN: 9783844394160 / Angielski / Miękka / 2011 / 120 str. Termin realizacji zamówienia: ok. 10-14 dni roboczych. |
cena:
220,21 |
 |
Energy Conservation Methods in Juice Concentration by Evaporation
ISBN: 9783844385700 / Angielski / Miękka / 2011 / 120 str. Termin realizacji zamówienia: ok. 10-14 dni roboczych. In many food processes water, or another solvent, needs to be removed from a dilute liquid to produce a concentrated or dried product. One of the processes that can be used to remove water is evaporation. Evaporation has several advantages over other water removal processes. Modern evaporation plants are very effective at utilizing small amounts of steam or electrical energy to generate large rates of evaporation. Techniques such as multiple- effect evaporation, thermal vapor recompression and mechanical vapor recompression greatly reduce the amount of energy required to give a certain degree...
In many food processes water, or another solvent, needs to be removed from a dilute liquid to produce a concentrated or dried product. One of the proc...
|
cena:
220,21 |
 |
Promoting Democracy: The Force of Political Settlements in Uncertain Times
ISBN: 9781479811380 / Angielski / Twarda / 2019 / 320 str. Termin realizacji zamówienia: ok. 30 dni roboczych. |
cena:
387,71 |
 |
Nen'ütonowskie swojstwa fruktowyh koncentratow
ISBN: 9786203004113 / Rosyjski / Miękka / 116 str. Termin realizacji zamówienia: ok. 10-14 dni roboczych. |
cena:
111,45 |
 |
Brucelosis... ¡De la (A) a la (Z)!
ISBN: 9786200392510 / Hiszpański Termin realizacji zamówienia: ok. 10-14 dni roboczych. |
cena:
323,12 |
 |
Brucellosi ... Dalla (A) alla (Z)!!!
ISBN: 9786204889351 / Włoski / Miękka / 164 str. Termin realizacji zamówienia: ok. 10-14 dni roboczych. |
cena:
323,12 |
 |
Les femmes dans le mouvement islamique marocain al-Adl wa al-Ihsan
ISBN: 9786205442876 / Francuski / Miękka / 108 str. Termin realizacji zamówienia: ok. 10-14 dni roboczych. Discuter de l'islamisme devient plus complexe lorsque l'on évoque la perception qu'ont les islamistes des questions relatives aux femmes. En fait, cette idée constituera l'essentiel de ce document de recherche. Ce document de recherche se penchera sur deux questions polémiques. La première est le féminisme islamique et la seconde le féminisme islamique dans le groupe islamiste marocain al-Adl wa al-Ihsan (justice et spiritualité). Les groupes islamistes sont souvent décrits, tant par l'Occident que par les régimes locaux, comme étant en retard sur la modernité. De même, les femmes...
Discuter de l'islamisme devient plus complexe lorsque l'on évoque la perception qu'ont les islamistes des questions relatives aux femmes. En fait, ce...
|
cena:
273,68 |
 |
Pedagogies of Deveiling: Muslim Girls and the Hijab Discourse
ISBN: 9781617357220 / Angielski / Miękka / 2012 / 186 str. Termin realizacji zamówienia: ok. 30 dni roboczych. Manal Hamzeh's book, Pedagogies of deveiling: Muslim girls & the hijab discourse, presents an exploration of a gendering discourse, the hijab (veil) discourse, and how it was negotiated by four girls who self-identified as Muslims. Pedagogies of deveiling emerged over a period of three years writing up a 14 months long study in which Hamzeh collaborated with four Muslim girls in two US southwestern border towns between October 2005 and December 2006. This book stems from the stories of these four Muslim girls weaved with Hamzeh's stories and perspectives as arabyyah-muslimah, the main... Manal Hamzeh's book, Pedagogies of deveiling: Muslim girls & the hijab discourse, presents an exploration of a gendering discourse, the hijab (veil... |
cena:
206,64 |
 |
Propriétés non newtoniennes des concentrés de fruits
ISBN: 9786203004168 / Francuski / Miękka / 116 str. Termin realizacji zamówienia: ok. 10-14 dni roboczych. Il existe un grand nombre d'ouvrages sur la rhéologie des aliments, car l'étude de la rhéologie des aliments implique des facteurs uniques au-delà de la compréhension de la dynamique rhéologique de base de l'écoulement et de la déformation de la matière. Les aliments peuvent être classés en fonction de leur état rhéologique, comme un solide, un gel, un liquide, une émulsion avec les comportements rhéologiques associés, et leurs propriétés rhéologiques peuvent être mesurées. Ces propriétés affecteront la conception des usines de transformation des aliments, ainsi que la...
Il existe un grand nombre d'ouvrages sur la rhéologie des aliments, car l'étude de la rhéologie des aliments implique des facteurs uniques au-delà...
|
cena:
170,32 |
 |
Photo-assisted Kelvin Probe Force Microscopy Investigation of Three-dimensional GaN Structures
ISBN: 9783844086744 / Angielski / Miękka / 2022 / 170 str. Termin realizacji zamówienia: ok. 30 dni roboczych. |
cena:
235,62 |












